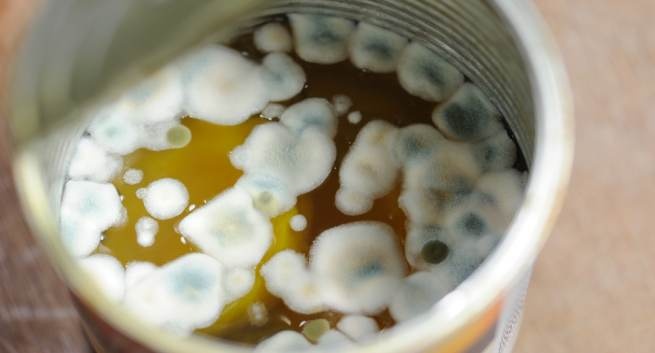

Người phụ nữ 54 tuổi bị ung thư gan vì sai lầm khi chế biến món này
Nghe nói nấm tuyết có tác dụng đẹp da nên bà Triệu (Trung Quốc) năm nay 54 tuổi mua rất nhiều để nấu cháo và uống.
Do bận rộn, bà thường ngâm rất nhiều nấm tuyết 1 lần, sau đó khi cần dùng thì lấy ra 1 ít.
Một ngày nọ, bà Triệu đột nhiên bị đau bụng dữ dội vào lúc nửa đêm, và ngay lập tức gọi cấp cứu. Kết quả là chỉ số alpha-fetoprotein trong huyết thanh đã lên tới 580, bác sĩ cho biết bà bị ung thư gan giai đoạn cuối và bà đã qua đời sau 2 lần hóa trị. Bác sĩ giải thích: Nấm tuyết sau khi ngâm lâu có thể sinh ra axit men gạo, đây là một loại chất gây ung thư, ăn thường xuyên có thể gây ung thư tế bào gan.
Các thực phẩm khác cực hại gan
1. Thực phẩm giàu chất béo
Mặc dù thực phẩm giàu chất béo có màu sắc, hương vị thơm ngon và có thể kích thích vị giác như gà rán, khoai tây chiên, thịt kho… nhưng nếu ăn chúng thường xuyên sẽ làm tăng gánh nặng cho gan và gây hại cho sức khỏe của gan.
Khả năng chuyển hóa chất béo của gan có giới hạn. Khi hấp thụ quá nhiều chất béo sẽ làm tích tụ quanh gan, khiến tế bào gan không được cung cấp đủ máu và oxy nuôi dưỡng, gây ra tình trạng thiếu oxy, hoại tử tế bào gan do thiếu máu cục bộ, làm giảm chức năng chuyển hóa của gan, lâu ngày gây gan nhiễm mỡ. Gan nhiễm mỡ đơn giản có thể hồi phục, nhưng nó có thể phát triển thành viêm gan nhiễm mỡ, xơ gan hoặc ung thư gan nếu không được điều trị.
2. Thức ăn ôi thiu
Bảo quản thực phẩm không đúng cách có thể dễ dàng sinh ra aflatoxin, đây là một chất gây ung thư đã được công nhận. Tiếp xúc thường xuyên có thể làm hỏng chức năng của tế bào gan, gây đột biến DNA của tế bào gan và cuối cùng gây ung thư gan. Thông thường, ngũ cốc và trái cây bị mốc có chứa chất này, dù chỉ một phần bị mốc cũng phải vứt bỏ. Nếu lỡ ăn phải hạt đắng, hãy nhổ ra và súc miệng.
3. Đồ chua, đồ hun khói
Các loại dưa chua và thịt xông khói, giăm bông, cá muối,… chứa rất nhiều nitrit. Nitrit có thể làm tổn thương niêm mạc dạ dày và gây viêm dạ dày mãn tính. Bên cạnh đó, nitrit được chuyển hóa ở gan tạo ra nitrosamine. Đây là một loại chất gây ung thư, có thể gây tổn hại đến sức khỏe của gan, dẫn đến thoái hóa và suy giảm tế bào gan, giảm sức sống của gan.
Làm thế nào để bảo vệ gan?
1. Ăn nhiều rau quả tươi
Rau tươi và trái cây chứa nhiều chất xơ, vitamin và nguyên tố vi lượng, có thể giảm bớt gánh nặng giải độc cho gan, đặc biệt là cà rốt. Cà rốt chứa resveratrol, có thể ức chế sự phát triển của tế bào ung thư. Bên cạnh đó, cà rốt chứa vitamin A, vitamin E, có thể giúp loại bỏ các gốc tự do và tăng cường chức năng miễn dịch của gan.
2. Bổ sung chất đạm
Protein có thể thúc đẩy quá trình “sửa chữa” các tế bào gan bị tổn thương, tăng cường quá trình giải độc và trao đổi chất của gan, vì vậy mọi người cần cung cấp đầy đủ protein chất lượng cao như trứng, sữa, thịt nạc, đậu đỗ để bảo vệ gan.
3. Ngủ đủ giấc
Ngủ đủ giấc không chỉ nâng cao năng lượng mà còn bảo vệ gan, tăng lưu lượng máu đến gan, giúp tế bào gan có đủ thời gian để sửa chữa và tái tạo. Bạn nên đi ngủ trước 23h và nằm 30-60 phút nghỉ trưa trong ngày.
Ngoài ra, để nuôi dưỡng gan, chúng ta không nên uống nhiều rượu bia, không lạm dụng thuốc, duy trì tập thể dục điều độ, không quá lười biếng, giảm thiểu trạng thái tiêu cực. Những điều này giúp cải thiện tuần hoàn máu và thúc đẩy quá trình trao đổi chất ở gan. Bên cạnh đó, thường xuyên đến bệnh viện để kiểm tra chức năng gan và xét nghiệm alpha-fetoprotein để phát hiện sớm khi gan gặp vấn đề.
Trong cơ thể người, gan là cơ quan nội tạng lớn nhất, với vai trò thực hiện các nhiệm vụ quan trọng để duy trì sức khỏe.










